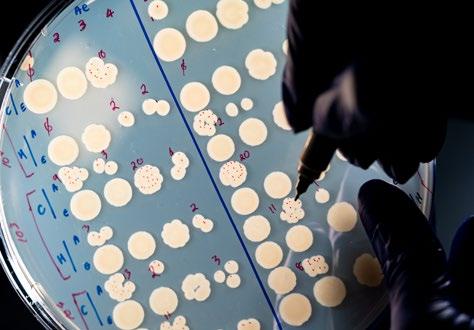

![]()


This quarter, St. Jude made meaningful advances across a wide spectrum of discovery ā from redefining fundamental biology to driving forward clinical innovation. Our scientists resolved debates in gene regulation, uncovered new mechanisms in immunity, and revealed how molecular pathways shape cancer and other diseases. Alongside this, clinical trials expanded treatment options for devastating pediatric conditions, demonstrating the lifesaving impact of earlier and more precise intervention. Together, these achievements reinforced the position of St. Jude as a global thought leader at the intersection of research, medicine, and impact.
Faculty and leaders at St. Jude were also recognized with prestigious national honors this quarter, reflecting both the groundbreaking research of our investigators and the visionary leadership guiding the institution forward.
St. Judeās pioneering expertise is being showcased through featured content on Nature platformsāsharing stories of research, discovery, and impact with a global audience. We work directly with Nature Research Custom Media to develop high-quality content that adheres to the Nature editorial standards. These articles create visibility and awareness around the research enterprise, initiatives, and those representing the organization.
In Q1FY26, we highlighted publications from St. Jude investigators who are accelerating our understanding and treatment of non-malignant hematological disorders through gene therapy approaches. Read more in the section of our collections page on nature.com titled: The promise of gene therapy for hematological disorders.
Learn more: The promise of gene therapy for hematological disorders



Aseem Ansari, PhD, and Tanja Mittag, PhD
Molecular Cell
⢠Scientists have debated how phase separation drives gene transcription (the process of turning DNA into RNA) and whether small, soluble protein complexes or larger, phase-separated droplets play a more significant role.
⢠To resolve the debate, St. Jude researchers engineered a transcription factor called Gnc4, adjusting its ability to form droplets, and tested how these changes affected gene activity.
⢠The findings revealed that common forces link both models and can drive transcription, though not always with equal benefit, providing a more nuanced understanding of gene regulation that could influence how researchers design new therapies targeted at cancer and other diseases.
H5N1 found in dairy cattle retains preference for infecting birds, representing low risk to humans
Richard Webby, PhD
Nature Communications
⢠The discovery of H5N1 avian influenza in U.S. dairy cattle raised urgent questions about whether the virus might adapt to spread efficiently among humans.
⢠St. Jude scientists analyzed cattle-derived viruses and found they remain more like avian influenza than human strains, retaining a preference for bird-like receptors, spreading only through direct contact (not through the air), and remaining sensitive to existing antiviral drugs and vaccines.
⢠These findings suggest the current risk of an associated human pandemic is low; however, they underscore the importance of vigilance, especially for farm workers and others in close contact with infected animals or raw milk.
Learn more: Visit the St. Jude Newsroom to read the full press release.
Learn more: Visit the St. Jude Newsroom to read the full press release.


Ben Youngblood, PhD; Caitlin Zebley, MD; Stephen Gottschalk, MD
⢠Infants with X-linked severe combined immunodeficiency (X-SCID), sometimes called ābubble boy disease,ā are born without functioning immune systems ā a life-threatening condition that St. Jude researchers treated with a safe and successful gene therapy in 2019.
⢠As the childrenās immune systems began to rebuild after therapy, scientists had a rare window into how human immunity develops from the very beginning, allowing them to track emerging cell types in real time.
⢠The study confirmed that āvirtual memoryā T cells, previously only seen in lab models, exist in early human immune development, opening new possibilities for vaccines and therapies that harness this first line of protection.
Chia-Hsueh Lee, PhD
⢠While sweet taste receptors allow us to detect sugar and sweeteners, the precise mechanism for how these receptors respond to different molecules has remained unclear.
⢠St. Jude researchers mapped the full range of motion of the sweet taste receptor as it interacted with two sweeteners, sucralose and advantame, and uncovered a previously unknown fully activated state.
⢠These insights not only reveal how sweetness is detected at the molecular level but also point the way toward designing improved sweeteners that could enhance taste while supporting better nutrition and health.
Learn more: Visit the St. Jude Newsroom to read the full press release.
Learn more: Visit the St. Jude Newsroom to read the full press release.


Madan Babu, PhD, FRS, and Giedre Krenciute, PhD
Molecular Therapy
⢠CAR Tācell therapy has shown great success against blood cancers, but it has struggled in solid and brain tumors, where cancer cells can hide by not displaying the same target protein.
⢠To address this, St. Jude scientists used an AI-informed method to design and test thousands of dual-target CAR T cells rapidly, identifying versions most likely to function effectively on the cell surface.
⢠The optimized bi-specific CAR T cells outperformed standard designs in preclinical models, demonstrating a powerful new strategy that could expand the reach of CAR Tācell therapy to more patients and tougher cancers.
Clinical trial shows newborns with spinal muscular atrophy (SMA) can start treatment at birth
Richard Finkel, MD
⢠Spinal muscular atrophy (SMA) is a devastating genetic disease that, without treatment, inhibits motor development in infants and often leads to death before age 2.
⢠In an international clinical trial co-led by Richard Finkel, MD, of St. Jude, researchers tested whether risdiplam, a drug previously approved only for infants 2 months and older, could be given safely and effectively within the first six weeks of life, before symptoms begin.
⢠The results showed remarkable motor development, with many children reaching milestones like sitting, standing, and even walking ā findings that prompted the FDA to extend risdiplamās approval to newborns and underscored the lifesaving power of earlier intervention.
Learn more: Visit the St. Jude Newsroom to read the full press release.
Learn more: Visit the St. Jude Newsroom to read the full press release.


Midkine
Junming Peng, PhD
Nature Structural and Molecular Biology
⢠Alzheimerās disease is driven in part by the buildup of amyloid beta proteins in the brain, which clump together and damage nerve cells.
⢠St. Jude researchers used advanced protein-mapping techniques to identify midkine, a protein that naturally accumulates in Alzheimerās patients and helps block amyloid beta from forming harmful assemblies.
⢠The discovery of midkineās protective role opens new possibilities for drug development aimed at mimicking this effect, pointing toward potential strategies to slow or prevent Alzheimerās disease.
Stephen Mack, PhD, and Richard Kriwacki, PhD
Nature Cell Biology
⢠Ependymoma, the third most common childhood brain tumor, has seen little progress in treatment for more than three decades, leaving families with limited options.
⢠St. Jude researchers discovered that the genetic fusion driving most cortical ependymomas forms tiny liquid-like droplets, called condensates, inside cells ā structures that help fuel tumor growth.
⢠While the fusion protein itself is difficult to target with drugs, the study points to new strategies for disrupting its partners within condensates ā an approach that could not only advance treatment for ependymoma, but also other cancers driven by similar fusion proteins.
Learn more: Visit the St. Jude Newsroom to read the full press release.
Learn more: Visit the St. Jude Newsroom to read the full press release.


New multi-disciplinary approach sheds light on the role of mitochondrial
Mondira Kundu, MD, PhD
⢠Mitochondria regulate a cellās energy and carry their own DNA which has been found mutated in cancer. Scientists have debated for years whether these mutations help tumors grow or are simply harmless passengers.
⢠Using advanced computational tools and a multi-layered sequencing approach, St. Jude researchers mapped mitochondrial DNA mutations in pediatric leukemias, showing how and when these mutations arise and how some may even contribute to therapy resistance.
⢠The findings establish a roadmap for understanding the role of mitochondrial DNA in cancer, opening the door to new strategies that could improve treatment and overcome drug resistance.
āMolecular glueā harnesses power of the immune system to treat neuroblastoma
Jun Yang, MD, PhD
Nature Communications
⢠Neuroblastoma, a childhood cancer, is difficult to treat because its tumor cells can exist in two different states and even switch between them, making therapies less effective and relapses common.
⢠St. Jude scientists studied the drug indisulam, a molecular āglueā that halts tumor growth, and discovered that while it faces challenges due to state-switching cells, it also sparks an unexpected immune response by drawing natural killer cells to attack the tumor.
⢠When combined with anti-GD2 immunotherapy to strengthen this immune activity, the treatment achieved complete tumor responses in models, pointing to a promising new strategy for children with this hard-to-treat cancer.
Learn more: Visit the St. Jude Newsroom to read the full press release.
Learn more: Visit the St. Jude Newsroom to read the full press release.

Doug Green, PhD
⢠A critical immune defense called LC3-associated phagocytosis (LAP) helps the body clear infections and fight cancer, but scientists did not understand exactly how this process begins, until now.
⢠St. Jude researchers discovered that the lipid phosphatidylserine acts as the trigger, enriching the phagosome membrane and recruiting the molecular machinery needed to launch LAP.
⢠By uncovering this lipid-driven mechanism, the study not only deepens understanding of immune regulation but also opens the door to therapies that could strengthen the bodyās defenses against cancer and other diseases.
Learn more: Visit the St. Jude Newsroom to read the full press release.

James R. Downing, MD, President and CEO of St. Jude Childrenās Research Hospital, has received notable recognition for his leadership and impact in health care, including induction into the 2025 Tennessee Health Care Hall of Fame and being named one of Beckerās ā95 academic medical center CEOs to know.ā These honors highlight his transformative contributions to pediatric cancer research, patient care, and the advancement of academic medicine.
Learn

Learn more: beckershospitalreview.com
Andrea Gropman, MD, has been honored with the 2025 Hower Award by the Child Neurology Society. This prestigious award recognizes her exceptional contributions to the field of child neurology, particularly in the areas of neurogenetics and rare diseases.
Learn more: childneurologysociety.org


Hongbo Chi, PhD, has been honored with the 2025 ICIS-BioLegend William E. Paul Award for Excellence in Cytokine Research. This prestigious award recognizes his pioneering work in immunometabolism and systems immunology, particularly his groundbreaking studies on the metabolic regulation of immune cell function.
Learn more: cytokinesociety.org


Spinal muscular atrophy (SMA) is a rare genetic condition that causes progressive muscle weakness, which, in its most severe form, prevents motor development in infants and typically leads to death before 2 years of age if untreated.
Richard Finkel, MD, a St. Jude investigator and leader in the Pediatric Translational Neuroscience Institute, began a firstof-its-kind trial of SMA treatment before symptoms begin manifesting in patients. The trial was a success, resulting in several children being able to stand and walk unassisted. This research was covered in Medscape and Medpage
āThis study showed that infants in whom type 1 SMA was predicted to develop who were treated presymptomatically with risdiplam within the first six weeks after birth survived without assisted ventilation and achieved motor milestones over a period of 24 months. These functional outcomes have not been attainable with supportive care alone.ā
- Richard Finkel, MD

In August 2025, TODAY.com featured the story of Fletcher Fazenbaker, a neuro-oncology patient who had been told by two separate institutions that there was nothing that could be done for her tumor. After filling out referral paperwork, they were then connected with Aditi Bagchi, MD, who diagnosed Fletcher with an infant-type hemispheric glioma and began treatment. Fletcher recently turned 3 and has been off treatment for nearly two years and is showing no signs of cancer.
āResearch over the last decade or so has slowly given us hints that these tumors, which these little babies are getting, are different from the glioma that we see in older individuals. Itās a relatively new reclassification.ā
-Aditi Bagchi, MD
MEDIA COVERAGE

Read more

Vibrio vulnificus, or flesh-eating bacteria infections, are impacting the food supply on the Gulf Coast, leading major media outlets, including Today, The Associated Press, Yahoo News, and U.S. News and World Report, to turn to St. Jude experts to understand the increase in infections and how to prevent them.
St. Jude researcher commentary has helped inform the public on the risks to coastal communities. This level of expertise and guidance serves to reinforce the continually growing reputation of St. Jude as a trusted thought leadership source when it comes to informing the public on multiple health care issues.
āWeāre in the middle of the hurricane right now; July and August are when all the [vibrio] action happens. The numbers are still not so high, but the most worrisome part is theyāre consistently increasing.ā
-Salvador Almagro Moreno, PhD

Over the summer, cases of Vibrio vulnificus, typically found on the Gulf Coast, increased. In addition to the increase in this area, the bacterium has also been found as far north as Cape Cod. While the increase has not risen to outbreak level, the estimated 82 confirmed cases, as of August, have been alarming. Of the 82 cases, 10 people have died.
Salvador Almagro Moreno, PhD, an associate member of the Department of HostāMicrobe Interactions, spoke to TODAY.com about the increase in cases of the virus and the connection to eating oysters caught on the Gulf Coast, as well as why the bacterium may be spreading.


Since March 2024, dairy cattle around the U.S. have been infected with H5N1, the first time infections in cows have been recorded.
More than a year later, experts are still trying to determine how the virus is spreading among cows on these farms, with some evidence indicating the virus is airborne. Whether the virus transmits through the air, milk, or other ways, dairy farm workers need to ensure they take extra precautions to protect themselves from infection, according to Richard Webby, PhD, during an interview with Scientific American.

āWeāve dodged a little bit of a bullet so far with cows and this virus. But itās a ridiculously contaminated environment [on dairy farms].ā
-Richard Webby, PhD

St. Jude is gaining recognition as a leader in the convergence of quantum computing, artificial intelligence (AI), and drug discovery. At the American Chemical Society Fall 2025 meeting, Christoph Gorgulla, PhD, assistant member in the Department of Structural Biology, presented groundbreaking work demonstrating how quantum computing, combined with AI, identified two novel inhibitors targeting the KRas protein ā a notoriously difficult cancer target. This innovative approach, which rapidly generated and tested over a million potential drug candidates, underscores the role of St. Jude at the forefront of computational medicine and positions its researchers as trusted thought leaders in the evolving landscape of precision oncology.



St. Jude is at the forefront of integrating virtual reality (VR) into pediatric care, enhancing both clinical practice and patient education. In a recent initiative highlighted by Fox13, St. Jude utilized VR technology to create immersive 3D models of tumors, enabling surgeons and families to explore and understand complex medical conditions collaboratively. This innovative approach not only aids in surgical planning but also empowers families to make informed decisions about their childās treatment. By leveraging cutting-edge technology, St. Jude continues to lead in patientcentered care, setting a benchmark for hospitals worldwide.
In a recent Medscape article, experts highlighted that survivors often experience a faster trajectory of aging compared to their peers, leading to an early onset of chronic conditions such as heart disease and cognitive decline.
St. Jude research has been instrumental in identifying the underlying causes of this accelerated aging, including the accumulation of acquired mutations in blood cells and the impact of chemotherapy treatments. This work underscores the leadership of St. Jude in advancing our understanding of cancer survivorship and its commitment to improving the long-term health outcomes of survivors of childhood cancer.





Sharing stories of impact and discovery across the St. Jude research enterprise.
Scientific advances make the mission of St. Jude Childrenās Research Hospital possible every day. St. Jude Progress tells the stories of those advances from the investigators, laboratory researchers and clinical scientists who are making them.
Scan the QR code to learn more about St. Jude Progress
